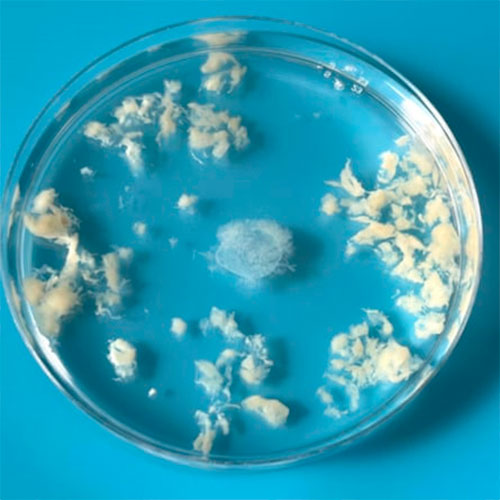
ayrylyan plasenta
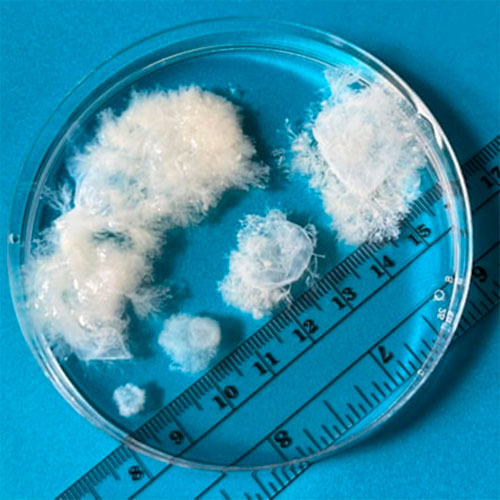
5 9 hepdelik gowrelilik

10 HEPDÄ ÇENLI GÖWRELILIK – SURATLARDA
ABŞ-nyň 13 ştatynda göwreliligiň irki döwürlerinde hem abort etdirmek gadagandyr. Emma göwrelilik dokumanyň aslynda nähili görnüşde bolýandygyna seýrek duş gelinýär.
Aborta garşy göreşýänleriň onlarça ýyllap dowam etdiren kampaniýalary netijesinde, bu günki gün ABŞ-nyň 14 ştatynda abort düýbünden gadagan ýa-da berk çäklendirilen ýagdaýdadyr. Käbir ştatlarda aborta indi lukmançylyk prosedurasy däl-de, ahlak meselesi hökmünde garalýar. Pensilwaniýa ştatynyň bir wagtky senatory, häzirki wagtda gubernatorlyga dalaşgär – Doug Mastriano – abort gadagançylygyny bozýan sahsyýetleri adam öldürmekde aýyplamaga çagyrýan köpsanly respublikan syýasatçylarynyň biridir.
Bu 14 ştatyň 13-de, göwreliligiň hatda gaty irki döwürlerinde hem abort etmek gadagandyr.
Bu suratlary biz MYA Tory atly, pandemiýa döwründe käbir ştatlarda aborta ‘möhüm däl’ lukmançylyk kömegi hökmünde seredilip başlanmagy netijesinde, bir ýere jemlenen lukmanlar we aktiwistler tarapyndan gurnalan topardan aldyk. Olarda göwreliligiň ilkinji 9 hepdesinde dokumanyň nähili görnüşde bolýandygy suratlandyrylýar.

4 hepdelik göwrelilik. Suratçy: MYA Tory
Ýokarda göwreliligiň başlangyç döwründe, desidual dokumanyň entäk 4 hepdelikkä ýagdaýy.
MYA torunyň agzasy, doktor Joan Fleýşman (Fleischman) desidual dokumany aýyrmak üçin el guralyny ulanýar. Dokumanyň şeýle seresap usulda alynmagy netijesinde, ol üýtgewsiz saklanýar.

5 hepdelik göwrelilik. Suratçy: MYA Tory
Ýokarda göwreliligiň 5 hepdelik wagty alnan desidual dokuma.
Kämahal pasientler abortdan soň dokumany görmek isleýär. Fleýşmanyň aýtmagyna görä, olar dokumanyň hakykatda nähilidigini görüp, haýran galýarlar. Ol bu barada: "Şonda men internetde we plakatlarda şeýle irki döwürdäki göwrelilik üçin hem eýýäm ynsan alamatlary bolan şekilleri suratlandyrmagyň medeniýetimize nä derejede ornaşandygyna göz ýetirdim. Sebäbi olar abort edilip alnan dokumanyň hakykatda şeýle görnüşdedigine hatda ynanmajak bolýalar" diýip belleýär.

6-hepdelik göwrelilik. Suratçy: MYA Tory
Ýokarda göwreliligiň 6 hepdelik wagty alnan dokuma, ýagny, "düwünçegiň ýürek urgusy" diýip ýalnyş atlandyrylýan, abortyň bikanun bolýan wagtky ýagdaýy.
Fleýşman: "Lukmanlar dogrum gününi kesgitlemek üçin, göwreliligi soňky aýbaşynyň ahyrky gününden hasaplaýarlar, emma aslynda ilkinji 2 hepdede entäk göwreli bolunmaýar" diýýär. Bu bolsa, abort alty hepdelige çäklendirilen ştatlarda, aýbaşysy gelmänden soňra, göwreli galan şahsyň abort etdirmegi üçin gaty az wagtynyň bardygyny aňladýar.
Internetde we okuw kitaplaryndaky suratlaryň aglabasy göwreliligiň bu möhletinde düwünçegiň gaty kämilleşen ýagdaýyny şekillendirýär.
Göwreliligiň irki döwürleri üçin beýle suratlaryň bolmagy, aborta garşy we ýaşaýşyň çaga galan pursatyndan başlanýandygyna ynanýan adamlar, ýa-da, aýallaryň öz göwreliligi barada joşgunly bolmagyny isleýän, prenatal muşdaklarynyň işidir.

7-hepdelik göwrelilik. Suratçy: MYA Tory
Ýokarda göwreliligiň 7 hepdelik wagtyndaky dokuma şekillendirilen we düwünçek entägem göze iler derejede däl. Düwünçek yumurtgajygyň (плодное яйцо) ululygy ýaňy 1 sm töweregi. Fleýşman: "Okuw-tejribe ýerinde boldum we hatda şo taýda-da, medisina talyplary we lukmanlar hem muny görende, entägem haýran galýarlar. Görüň, bu misinformasiýa (ýalan, nädogry maglumatlar) nähili derejede giňden ýaýrapdyr!" diýip belleýär.
Forumlarda okap, ýa-da internetde suratlary görüp, göwreliligiň bu möhletinde aýalllaryň aborta gorky bilen gelmekleri mümkindir. Fleýşman: "Bu aýallar köplenç özüni aldanan ýaly duýýarlar, çünki olar abort edip alnan düwünçegiň kiçijik eljagazlary bolan, eýýäm kämilleşen, kiçijik bäbejik görnüşinde bolmagyna garaşýarlar" diýýär.
Aýrylýan plasenta (çörekçe) (отпадающая плацента) we düwünçek ýumurtgajygy (плодное яйцо)
Suratçy: MYA Tory
Bu suratda göwrelilige goldaw berýän desidual barda we düwünçegi goldajak amniotiki (suwly) haltajyga öwrülýän göwreliligiň haltajygy şekillendirilendir. Eger-de biz oňa mikroskop astynda has ýakyndan seretsek, onda adam sypatlaryny görüp bilerismi?
Fleýşman: "Islendik zada, şol sanda sperma we tohumlandyrylýan ýumurtgalygy ulaldyp, ýakyndan seretsek, bu gaty täsin zatdyr. Emma bu biziň gündelik ýaşaýyşy görşümizden düýbünden başgaçadyr. Bu garaýyş meniň üçin gaty jaýdar, emma nämüçindir, bu biziň düşünjämizde ýok" diýip belleýär.

8-hepdelik göwrelilik. Suratçy: MYA Tory
Ýokarda göwreliligiň 8 hepdelik wagty aýrylan düwünçek yumurtgajygy (плодное яйцо). Bu surat göwreliligiň irki döwrüne degişli bolsa-da, MYA Tory abort etdirmegiň "gowy" ýa-da "erbet" wagty bar diýmeýär. Şeýle-de, islendik döwürde göwreliligiň kesilmeginiň emosional agyrdygyna hem göz ýummaýar. Emma onuň maksady, göwreliligiň irki döwründe abort edilip aýrylýan zadyň aslynda nähili görnüşde bolýandygyny ilata aýan etmekdir.
"Abort bu lukmançylyk idegidir. Bu netijä gelýän her bir şahs çylşyrymdyr. Emma desudial dokumanyň ilkinji 10 hepdedäki ýagdaýyny görkezýän maglumat, sözüň doly manysynda, biziň düşünjämizde ýokdyr we halk köpçüliginiň dogry maglumaty bilmäge haky bardyr".

9-hepdelik göwrelilik. Suratçy: MYA Tory
Bu suratda göwreliligiň 9 hepdelik wagtyndaky düwünçek yumurtgajygy (плодное яйцо) şekillendirilýär. Ýagny, göwreliligiň 9 hepdelik wagty abort edilip aýrylýan, ähli zady görkezýär. Emele gelen üwünçegi/embrionyentäk görmek mümkin däl diýen ýaly. Abort etdirmäne gelen birine muny görkezmek, olary birazam bolsa rahatlandyryp biler. "Köplenç abort etdirmekçi bolýan şahs bu barada başgalara söz açmaýar. Olar töweregindäkiler tarapyndan tankytlanmakdan gorkup, abort etmek baradaky karary sessiz we gizlin şekilde alýarlar. Soňra men ýatgynyň boýunjygyndan nem çyrşagyny alandan sähelçe köp wagt alýan, ýönekeý prosedurany amala aşyrýan. Dokumany görjek bolýanlaryň başda dartgynly ýagdaýdadyklaryny duýup bolýar. Çünki olar emosional durnuksyzlygy başdan geçirýärlerwe dokumany görenden soň olar, haýran galyp, ‘bary şujagazmy?’ diýip soraýarlar" diýip, Fleýşman gürrüň berýär.
Göwreliligiň 5 hepdeden 9 hepdä çenli geçiş döwri.
Suratçy: MYA Tory
Bu ýerde bolsa, bir gapjagaza ýerleşdirilen, göwreliligiň 5 hepdeden 9 hepdä çenli geçiş döwrini görkezýän birnäçe düwünçek yumurtgajyklary (плодные яйцa) şekillendirilendir. Ýumurtgajyklar her gün 1 mm ulalýar.
Näme sebäpli bu suratlara känbir duşmaýanlygymyz barada, MYA Torunyň agzasy, Dr. Mişel Gomez: "Men käbir lukmanlar näsaglaryň muňa nähili tasir etjekleri barada alada edýändirler diýip pikir edýärin. Emma adamlaryň muňa nähili garajagyna biz karar bermeli däl we muňa hakymyz hem ýokdyr. Biz diňe misinformasiýa garşy göreşmek üçin, bar bolan maglumaty we faktlary halka aýan etmek isleýäris. Aýtjak bolýanymyz: bu gorkunç, howply ýa zeperli zat däl. Bu bary-ýogy, bedeniňizde bar bolan zadyň suraty" diýýär.
- 4393 gezek okalan